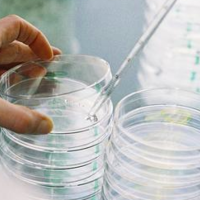

试管
"的相关帖子
上海试管婴儿哪个医院成功率最高多少钱
好的医院可以说是为试管婴儿的成功奠定了一定的基础,要知道北京、上海等一线城市比较发达,医疗技术也比较先进,因此会有很多医院开展试管技术。不少夫妻都想选择前往上海做试管,但是却因为医院和费用的问题为难了起来,那么,我们便来看一看上海试管婴儿哪个医院成功率最高多少钱。上海试管婴儿哪个医院成功率最高实际上,现在很多城市都有试管婴儿医院,作为一线城市的上海,比较大的试管医院有很多,但比较好的医院有上海第九人民医院、上海第一妇幼医院、上海红房子医院、仁济医院、上海瑞金医院、上海集爱医院、上海长征医院、新华医院、上海长海医院 、上海中山医院等,这些医院的成功基本都能够达到50%-60%左右,而且技...
做试管婴儿怎么做才好呢,要怎么提高成功率
很多人对于试管婴儿的内容充满了迷茫,而且还认为试管婴儿的流程很繁琐,有些朋友都不知道做试管婴儿怎么做才好,因此很多人会问试管婴儿的流程、注意事项,以及应该怎样提高成功率等问题。鉴于此,现在就来详细说说试管的流程要怎么做才好以及如何提高成功率。做试管婴儿怎么做才好呢1、控制性超排卵由于自月经周期的长短因人而异,同一患者不同周期也存在差异,所以不易安排取卵时间,而且自然周期中只有一个优势卵泡发育,受精后只能形成一个胚胎,而移植一个胚胎的妊娠率是很低的。所以需要采用控制性超排卵来增强与改善卵巢功能,以达到不受自然周期的限制、获得多个健康卵子的目的,提供多个胚胎移植,并尽可能使黄体发育与子宫内膜功能...

泰国做试管婴儿最好的医院是哪一家
相比很多人度听说泰国的试管婴儿成功率很高,因此不少家庭已经开始“跃跃欲试”了。一说到泰国的试管婴儿,那么就不得不提医院这个话题了,这也是试管家庭关注的焦点,毕竟试管助孕从前期身体检查开始一直到后期验孕阶段,有80%以上的环节都在院进行。选择一家正规、专业且成功率高医院进行IVF,试管好孕几率有一定的保障。那么,泰国做试管婴儿最好的医院是哪一家呢?泰国做试管婴儿最好的医院是哪一家泰国的试管婴儿医院很多,但是比较热门的有这几家:泰国ibaby生殖中心、Jetanin杰特宁试管婴儿专科医院、BNHHospital医院、泰国碧雅威(Piyavate)国际医院、Vejthani Hospita...

现在做试管婴儿多少钱
试管婴是一种辅助生殖技术,可以帮助不孕夫妇解决生育问题。随着辅助生殖技术 的不断完善,试管婴儿被越来越多的夫妇所接受。现在许多正常夫妇也想选择试管婴儿技术来帮助怀孕。但是对于一些家庭来说,试管婴儿的费用就是一笔令人生畏的“巨资”,那么现在做试管婴儿多少钱呢?现在做试管婴儿多少钱事实上,无论哪一个生殖科医生都不建议正常人做试管婴儿,因为试管婴儿只是一种助孕手段,是必须采用的辅助生殖技术。并且做试管婴儿必须符合其适应症才能做到,试管婴儿分为一代、二代和三代,针对不同的病人有不同的适应症。而且做试管婴儿的费用也各不相同,每个人做试管婴儿的费用取决于病人的身体状况,如用药剂量、助孕时间等。每一个人...

成都试管婴儿哪家最好能花多少钱
如果要做试管婴儿,那么大家关注的必然是一个医院的好坏以及试管的费用。很多人都知道做试管婴儿治疗,首先要选择由国家卫建委批准,具有试管婴儿资质的正规医疗机构。但是关于费用问题就鄙是很清楚了,今天我们就来看一看成都试管婴儿的医院哪家最好,能花多少钱,预估一下试管的费用吧。成都试管婴儿哪家最好随着试管婴儿的普及和发展,现在很多城市都有了试管婴儿医院,而且很多城市还不止一两家,现在成都已经有10家医院具备试管婴儿的资质了,如四川省妇幼保健院、成都市妇幼儿童中心、四川华西第二医院、四川省人民医院、西南医科大学附属医院等,其地方都聚集在成都,医疗资源基本也在成都。虽然说成都的试管婴儿发展的没有北京、上海...

泰国试管婴儿需要多长时间完成
近两年来,泰国的试管婴儿因为成功率比较高而受到不少不孕不育家庭的关注,也想着到泰国尝试做试管。但是由于试管需要一定的周期,而且到国外做试管肯定也不如国内的方便,因此很多人会考虑到试管时间的问题。那么,泰国试管婴儿需要多长时间完成呢?泰国试管婴儿需要多长时间完成相信很多人都知道在国内做试管一般一次大约需要2-3个月的时间,但在泰国却不一定了。泰国试管婴儿需要多长时间完成是没有统一天数的,因为每个人的治疗周期不一样,具体的时间也不一样,每个人的时间不一样具体的时间需要根据自己的实际情况来确定的,在做试管婴儿前了解试管婴儿术前的注意事项,选择最佳的试管婴儿就诊时间,保养好身体,保持规律的良好作息,...

买卵做试管婴儿的价格是多少
目前,高龄女性做试管婴儿有两种方式:一是用自己卵子做;二是借用第三方健康卵子。很多高龄女性由于身体原因而没法使用自己的卵子,那么只能采用第二种方法了,但是买卵做试管婴儿的价格是多少呢,会不会比普通的试管婴儿贵?一起来看一下。买卵做试管婴儿的价格是多少我们都知道,女性生育能力与年龄有很大关系。从生理规律来讲,25-30岁女性的生育能力最佳的,到了45岁左右时生育期已经接近尾声,能自然受孕的几率非常渺小,即使能怀孕,出现流产、胎儿畸形的风险也会明显高于年轻女性。年龄越大的女性,自然受孕几率越小,做试管婴儿成功的几率同样如此。临床数据显示,40-45岁的女性做试管婴儿成功率只有20%左右,45岁以...

贵州哪家医院做试管婴儿比较好
受不孕不育困扰一直没能如愿生孩子的家庭最想了解的莫过于怎么做试管婴儿,在哪做试管婴儿最好。虽然说试管的成功率更多看个人,但是一家好的试管医院可以带来很大的保障。现在就来看一看贵州哪家医院做试管婴儿比较好。贵州哪家医院做试管婴儿比较好目前,贵州省可以做试管婴儿的医院共有6家,分别为贵阳市妇幼保健院、贵州医科大学附属医院、遵义医科大学附属医院、贵州省人民医院、黔东南州中医医院、贵阳市第二人民医院。要说在贵州可以做试管婴儿的医院里分出医院的高低,那么就没办法确定了。每家医院都有各自擅长的领域,而且在试管婴儿方面都取得了很大的成就,如贵州医科大学附属医院的生殖医学中心在2018年完成中心门诊量达78...

曼谷试管婴儿专业翻译怎么找,如何收费?
相信很多人都听说泰国的试管婴儿技术很成熟,而且成功率比较高,因此不少夫妻就像到泰国做试管婴儿。毕竟是不同的国度,在语言沟通方面就会面临问题,这时候,寻找一个靠谱的翻译很重要,但是曼谷试管婴儿专业翻译怎么找,如何收费?曼谷试管婴儿专业翻译怎么找1、赴泰国试管婴儿找专业的翻译,最好找有多年的试管婴儿行业翻译经验,对于医生以及报告能准确无误的翻译出来,其次要找正规机构,一般试管婴儿中介机构都有专业的翻译服务,建议可以向试管婴儿中介机构咨询。要知道找到一个专业的泰国试管翻译可以帮助更好的应该试管过程中遇到的问题,同时也能给夫妻实用的建议,加上专业的医疗翻译,和医生交流起来也会更加的熟练畅通。2、找泰...

试管婴儿费用包括哪些,总共多少
许多人对试管婴儿技术并不了解,试管婴儿是体外受精-胚胎移植技术的俗称,是指采用人工方法让卵细胞和精子在体外受精,并进行早期胚胎发育,然后移植到母体子宫内发育而诞生的婴儿。在试管婴儿费用方面也还有很多人存在疑虑,因为试管婴儿费用并非固定,要根据个人的实际身体情况选择不同方案,其个体差异很大,而且试管费用包含了很多方面,受众多因素影响,所以价格不同。那么,试管婴儿费用包括哪些,总共多少呢?试管婴儿费用包括哪些试管婴儿的费用一般主要包括三个部分:试管婴儿术前检查费、试管婴儿药物费用、移植手术及实验室费用。1、术前检查费用包括:血型、血常规,肝功能、肾功能,乙肝、丙肝检查,精液检查,阴道分泌物的检查...

十堰试管婴儿成功率如何,费用多少
试管婴儿的流程比较多,包括检查、促排、取卵、取精、受精、培养、移植、验孕、保胎等等步骤,每一步都不能有丝毫差错,每一步都会影响到试管婴儿成功率。要论试管婴儿的成功率是多少,每个国家、地区,或者是不同医院,甚至是每个人都不一样,但这是广大试管夫妻一直以来最关心的问题,现在就来看一看十堰这一座城市的试管婴儿成功如何,费用是多少吧。十堰试管婴儿成功率如何要知道现在的试管婴儿有三种不同的技术,每种试管技术的流程不一样,适用的人群也不同,因此成功率方面也会有所差异。一代试管因为采用的是精子和卵子自然结合的方式,与自然受孕情况差不多,只是精卵结合的地点从女方输卵管转移到器皿中。所以一代试管的成功率相对较...

邯郸试管婴儿哪里能做,费用是多少
选择试管婴儿医院的问题一直是大家比较关注的一个问题,其实网上对于试管婴儿医院的很多评论都是众说纷纭,以至于想要做试管的朋友不知道该作何选择,那么在邯郸有哪些医院可以做试管呢,费用大概是多少?一起来看看。邯郸试管婴儿哪里能做如今很多城市都会有试管婴儿医院,而且部分城市还会有很多,例如北京、上海、广州、深圳这类的一线城市。虽然说邯郸的经济和科技没有这些一线城市发展好,但是也有医院能够开展试管婴儿技术,那就是邯郸市中心医院和邯郸市妇幼保健院。这两所医院都是公立医院,所以不用担心被坑,价格都是公开透明的。有需要的朋友根据自己的情况进行选择即可。邯郸试管婴儿费用是多少一般情况下,第一、第二代试管婴儿费...

做试管婴儿哪里好一点,国内技术成熟吗?
现在国内的试管婴儿技术已经发展将近四十年的时间,在国内能做试管婴儿的医院有非常多,而随着现在国内对于试管婴儿技术的需求也越来越多,越来越多的人想要选择更好的地方去做试管婴儿。那么,做试管婴儿哪里好一点,国内技术成熟吗?做试管婴儿哪里好一点现在几乎每个省市都已经有能做试管婴儿资格的医院了,但是每个地方发展的速度不同,所以也不是每个医院做试管婴儿的成功率都是一样的,要清楚理智的认知这一点,不要觉得只要是个医院都可以。要说国内做试管婴儿哪里好一点,像北京这种地方不论是经济还是科技都会比较发达,可以开展试管婴儿的医院有很多,例如北京医科大学第三医院、北京朝阳医院等等。除了北京之外,其他的地方做试管婴...

试管婴儿需要多久去一次医院
试管婴儿一般都需要去医院进行检查,而且最开始的时候是取卵,卵子以精子结合形成胚胎以后,再将胚胎移植到女性的子宫中,移植之后还需要进行验孕。这些环节都是需要去医院的,有些不孕不育的夫妻就担心需要频繁的跑医院而耽误了工作,那么试管婴儿需要多久去一次医院呢?试管婴儿需要多久去一次医院一般来说,需要做试管婴儿的夫妇,从最初的术前检查、进入周期,到最后的胚胎移植成功怀孕,如果一切顺利,这个过程大约是2-3个月。一般情况而言,从正式进入试管婴儿周期开始到结束,期间需要前往医院数十次左右。但是具体间隔多久的时间去一次医院就要看个人的情况了,就拿术前检查来说,有些检查是在女性来月经的2-3天进行的,这就要看...

试管婴儿成功率有多少?没有输卵管能做试管婴儿吗
试管婴儿就像很多不孕不育夫妻手里的“救命稻草”,哪怕是微乎其微的机会,大家也想牢牢把它抓紧了,但是试管婴儿的费用比较高,常常让一些家庭望而却步,有的人做试管八九次才成功,而有的只需要一两次就能够成功。而关于不孕不育的成因有很多,比如男性的少精、弱精,或者女性的子宫、输卵管等问题,很多人知道自己身体存在这方面的问题而不能生育,但是却不确定自己能够否试管婴儿。所以,我们一起来看看试管婴儿成功率到底有多少,没有输卵管还能不能做试管婴儿。试管婴儿成功率有多少?现在,全国的试管成功率在40%-50%左右,没有具体的数值,因为成功率和很多因素有关,比如女性的年龄,如果女性年龄在35岁以下,没有其他的疾病...

一次试管婴儿多少钱,普通的家庭能做吗?
相信大家对于试管婴儿并不陌生了,随着不孕不育人数的增多,试管婴儿技术也变得越来越普遍。而且,我们也知道做试管婴儿是需要一大笔费用的,现在还有很多不孕不育家庭深受困扰,想通过试管生孩子,但是会因为不清楚试管的费用而犹豫。那么实际上一次试管婴儿多少钱,普通的家庭能做吗?一次试管婴儿多少钱现在在国内一次试管婴儿治疗费用一般在四万至八万左右不等,和个人的病情、病史都有一定的关系,早期治疗费用较低,需要花销的费用主要有术前检查费用、促排卵费用和手术费用这三大部分,其中不同的人就会产生不一样的费用了。比如,排卵费用,对于排卵障碍的患者,医生会通过促排卵药物进行诱导排卵,但是每个人的自身情况不一样,用药情...

陕西可以做试管婴儿的医院有哪些,哪家做的比较好
很多不孕不育夫妻在进行相关的治疗之后无奈选择了试管婴儿,但是还有很多人不清楚应该要怎么选择试管婴儿医院,毕竟每个人都希望能够找到一家好的医院,这样可以避免走弯路。所以,现在就来说说大家比较关心的试管婴儿医院问题,看一看陕西可以做试管婴儿的医院有哪些,哪家做的比较好。陕西可以做试管婴儿的医院有哪些试管婴儿对医院的各方面要求很高,并不是每个医院都能够开展试管技术的。据统计,目前陕西能够开展试管婴儿的医院共有14家,其中三甲医院有12家,它们分别是西北妇女儿童医院、唐都医院、西京医院、西安市人民医院、西安交通大学第一附属医院、安康市中心医院、宝鸡市妇幼保健院、西安儿童医院、陕西省中医医院、西安交大...

四川试管婴儿费用多少钱
试管婴儿是“体外受精-胚胎移植”技术通俗叫法,试管婴儿并不是指在试管中培育长大的婴儿,和普通的怀孕一样,试管婴儿也是需要在母亲的子宫内经过发育才能分娩的。试管婴儿的费用是很多人都关注的一个重点问题,那么现在就来看一下四川的试管婴儿费用大概是多少吧,给有需要的朋友提供一些参考。四川试管婴儿费用多少钱正常来说,四川试管婴儿的单期试管费用大概在三万多到四万多左右,但是不同的城市、不同医院以及个人之间的费用会有所差异,不过大体来说试管费用可以分为四个大的部分:1、检查费用,检查是试管婴儿进周之前必不可少的步骤,这个阶段夫妻双方都需要做必要的身体检查,夫妻双方全套的检查做完之后需要的费用大约在6千至7...

高龄试管婴儿注意什么
如今的三胎政策已经开放了,但是还有不少高龄家庭对于二胎还在跃跃欲试,但因为高龄的原因,身体各机能逐渐走下坡,自然怀孕非常难,所以只能借助试管婴儿助孕。由于年龄的原因,身体的情况都不如年纪轻的女性容易受孕,做试管婴儿虽然是比较好的选择,但是也是有很多方面要注意的。那么,高龄试管婴儿注意什么呢?高龄试管婴儿注意什么虽然很多人都可以做试管婴儿,但影响成功率的因素也有很多,其中年龄就是最大的因素。女性的年龄是试管婴儿成功率的关键,所以要想成功怀孕,最重要的就是把握好时间。因为女性卵巢里面的卵泡数量和卵子质量会随着年龄增长而减少,甚至变差。超过35岁之后,怀孕能力就会逐渐下降,如果还一直拖着,到后面就...

上海做试管婴儿要多少钱,需要去医院几次
上海是一线城市,在日常中的消费都比较高,由于其医疗技术也比较发达,很多不孕不育家庭就将试管的目光投向了上海,但是都会担心试管的费用太贵承担不起,而且如果是外地的话,还要频繁的晚往返医院会不方便。那么,现在就来看看上海做试管婴儿究竟要多少钱,需要去医院几次吧。上海做试管婴儿要多少钱试管婴儿每个步骤都有不同的收费标准,大家需要根据实际经济情况而定了。试管婴儿整体费用情况不尽相同,总的来说,如果是做一、二代试管大概需要3到5万。如果是第三代试管婴儿的话,那么费用就会更高,整体下来需要大概需要十万。因为上海做试管婴儿要多少钱是因人而异的,其中包含了前期检查、促排、取卵、胚胎移植等手术操作费用,每个人...
-
早上5一6点同房会怀男孩吗?一文揭开生育时间的科学真相
 4
4
-
dha什么牌子最好,有纽曼斯、童年时光以及佰澳朗德
 6
6
-
生儿子的碱性食物水果,常见的有香蕉、西瓜、樱桃
 4
4
-
什么姿势容易生儿子,民间流传后入式以及传教士等
 6
6
-
基础卵泡3个取了8个,通常来讲是比较正常的
 5
5
-
卵泡生长速度对照表,成熟期直径最大
 6
6
-
药流排出的孕囊什么样子,通过图片可以看出是粉白色的组织
 6
6
-
新生儿湿疹什么样子,新手爸妈必读的皮肤警报手册
 5
5
-
孕妇胃疼一招搞定5分钟,热敷、运动以及饮食等方法
 7
7
-
十大强碱性食物排名,科学看待均衡营养
 5
5
-
我还在哺乳期,最近感觉不太对劲,会不会又怀孕了?
 35
35
-
我孩子的体检报告上写着"年生长评价不合格",这是什么意思啊?
 30
30
-
我在网上看到用盐水可以验孕,这种方法靠谱吗?
 22
22
-
听说女人天天吃鸽子蛋特别好,是真的吗?
 30
30
-
我家宝宝早产要住保温箱,这个费用能报销吗?
 20
20
-
听说三个月B超能看出男女,是真的吗?
 25
25
-
想给宝宝换奶粉牌子,直接换可以吗?
 30
30
-
家里老人说宝宝未满月不能带出门,这有科学依据吗?
 49
49
-
我这次配成了三级胚胎,移植成功率大概有多少啊?
 17
17
-
我产假马上休完158天了,想问下还能继续休公休假吗?
 43
43
-
50岁去泰国试管婴儿好吗,值不值得去
 7492
7492
-
试管医院一般周六日的医生靠谱吗
 7666
7666
-
试管失败医院有责任吗,试管失败责任在谁
 7908
7908
-
囊胚4bc几乎是女孩,有事实依据吗?
 5465
5465
-
卖精子合法吗,供精试管的精子买的吗
 7517
7517
-
试管怀孕八个月还能上班吗,是不是可以休产假了?
 8573
8573
-
囊胚bc级什么意思,质量好与坏?
 5578
5578
-
试管823胚胎什么意思,是哪种等级的胚胎?
 5148
5148
-
治疗子宫肌瘤才能做试管婴儿吗,医生怎么说
 5674
5674
-
试管怀孕能吃辣椒吗?怀孕后是否要忌辣?
 4623
4623






